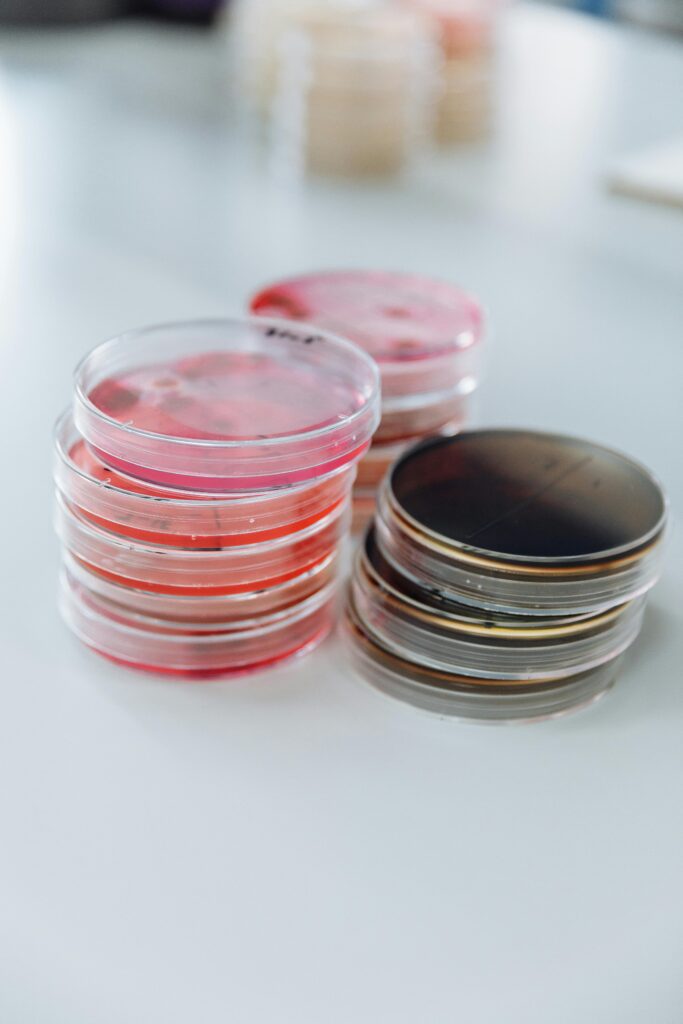

Tips Menentukan Jadwal Resepsi yang Tepat
Tips Menentukan Jadwal Resepsi yang Tepat Halo calon pengantin! Menentukan jadwal resepsi yang tepat adalah salah satu hal yang paling penting dalam perencanaan pernikahan. Karena itu, kita perlu mempertimbangkan beberapa hal sebelum menentukan jadwal resepsi yang sesuai dengan kebutuhan dan keinginan kita. 1. Tentukan Tanggal Pernikahan Sebelum menentukan jadwal resepsi, kita perlu menentukan tanggal pernikahan […]
Tips Menentukan Jadwal Resepsi yang Tepat Read More »